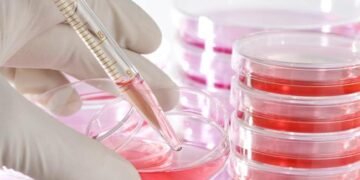
টেবলেট খালেই নিৰ্মূল হ’ব ব্লাডকেন্সাৰ! নতুন ঔষধ আনিছে এই দেশে, কিমান দাম হ’ব ভাৰতত এই ঔষধৰ?

টেবলেটেই ভাল কৰিব কৰ্কট! তেজৰ কৰ্কট নিৰ্মূল কৰিবলৈ নতুন ঔষধ আৱিষ্কাৰ কৰিছে এইখন দেশে৷ গ্লেনমাৰ্ক ফাৰ্মাছিউটিকেলে এই ঔষধ তৈয়াৰ কৰিছে৷ আমেৰিকাৰ এই ঔষধ নিৰ্মাতা সংস্থাৰ ৱৰ্কছপ আছে ভাৰততো৷ সংস্থাৰ তৰফৰ পৰা জনোৱা হৈছে যে ভাৰতীয়সকলৰ শাৰীৰিক সক্ষমতা বুজিয়েই এই ঔষধ তৈয়াৰ কৰিছে গ্লেনমাৰ্কে৷ এক নিৰ্দিষ্ট ডজত খালে কৰ্কটৰ কোষৰ বৃদ্ধি আৰু বিভাজন ৰৈ যাব বুলি দাবী সংস্থাটোৰ৷
লিউকেমিয়া বা তেজৰ কৰ্কটৰ নাম শুনিলেই ৰোগীৰ মাজত আতংক বাঢ়ে৷ আতংকিত হোৱাৰেই কথা৷ এটা সময়ত তেজৰ কৰ্কট ধৰা পৰা মানেই মৃত্যুভয়৷ কাৰণ ধাৰণা কৰা হৈছিল যে বাচি থকাৰ কোনো ৰাস্তা নাই৷ আৰু ক্ৰনিক মায়েলয়েড লিউকেমিয়াৰ দৰে তেজৰ কৰ্কট ধৰা পৰিলে মৃত্যু অনিবাৰ্য বুলিয়েই ধৰা হৈছিল৷ কাৰণ অস্থিমজ্জাৰ পৰা দ্ৰুতগতিত তেজলৈ বিয়পি পৰিছিল এই কৰ্কট৷ যিমান দিনত ইয়াৰ উপসৰ্গ ধৰা পৰে সিমান দিনে কৰ্কটে ফৰ্ট ষ্টেজেই পায়গৈ৷ কিন্তু এতিয়া তেজৰ কৰ্কটৰ নানান চিকিৎসা পদ্ধতি আহিছে৷ ৰেডিঅথেৰাপি আৰু কেমোথেৰাপিৰ যন্ত্ৰণা কমাবলৈকো ইমিউনোথেৰাপি আৰু মোনোক্লোনেল এণ্টিবডিৰে চিকিৎসাও কৰা হয়৷ কিন্তু লিউকেমিয়াৰ নিৰায়মত খোৱা ঔষধ আমাৰ দেশত নাছিল৷ গ্লেনমাৰ্ক ফাৰ্মাছিউটিকেলে এই প্ৰথম খোৱা টেবলেট আৱিষ্কাৰ কৰিছে৷
নতুনকৈ আৱিষ্কাৰ কৰা ঔষধবিধৰ নাম জানুব্ৰুটিনিব৷ ব্ৰুকিনছা ব্ৰেণ্ডৰ নামত বিক্ৰি হব এই ঔষধ৷ এই ঔষধৰ ক্লিনিকেল ট্ৰায়েল বহু দিন ধৰিয়েই চলিছিল৷ কৰ্কটত আক্ৰান্ত ৰোগীক ঔষধবিধ খোৱাই ভাল ফল পোৱা গৈছে বুলিও দাবী কৰা হৈছে৷ ট্ৰায়েলৰ ৰিপৰ্টৰ পাছতেই ঔষধবিধৰ উৎপাদন আৰু বিক্ৰিত অনুমোদন দিছে কেন্দ্ৰীয় ড্ৰাগ নিয়ামক সংস্থাই৷
তেজৰ কৰ্কট বহু ধৰণৰ হয়৷ যাৰ মাজত এবিধ হৈছে ক্ৰনিক মায়েলয়েড লিউকেমিয়া৷ ই মূলত শ্বেত ৰক্তকণিকাৰ কৰ্কট৷ অস্থিমজ্জাৰ যি ষ্টেম কোষে ৰক্তকণিকা তৈয়াৰ কৰে, সেই কোষৰ অস্বাভাৱিক আৰু অনিয়ন্ত্ৰিত বৃদ্ধি আৰম্ভ হলে এই কোষ কৰ্কটৰ কোষলৈ বদলি হয়৷ এই মায়েলয়েড কোষৰ পৰাই কিন্তু লোহিত কণিকা, শ্বেত ৰক্তকণিকা, অনুচক্ৰিকা তৈয়াৰ হয়৷ মায়েলয়েড কোষ যদি লেকামহীনভাৱে বিভাজিত হৈ থাকে তেতিয়া ৰক্তকণিকাসমূহৰ উৎপাদন প্ৰক্ৰিয়াও ব্যাহত হয়৷
শ্বেত ৰক্তকণিকাৰ সংখ্যা অস্বাভাৱিক হাৰত বাঢ়ি থাকে আৰু জমা হৈ পৰে অস্থিমজ্জাত৷ তাৰ পৰা তেজৰ মাধ্যমেৰে সমগ্ৰ শৰীৰত বিয়পি পৰে৷ কৰ্কটৰ কোষ এইদৰে বিয়পি পৰাৰ পৰা দেহক ৰক্ষা কৰিবলৈকে এই নতুন ঔষধ বুলি দাবী কৰিছে গৱেষকে৷
দাম কিমান?
দেশৰ বজাৰত এক বক্স জানুব্ৰুটিনিব ঔষধৰ দাম হব ২০ হাজাৰৰ পৰা আঢ়ৈ লাখৰ মাজত৷ কোন কোম্পানীয়ে এই ঔষধ বিক্ৰি কৰিব সেই অনুসৰি দাম ঠিক হব৷ এক বক্সত ৮০ মিলিগ্ৰাম ডোজৰ প্ৰায় ১২০ টা টেবলেট থাকিব৷ ক্ৰনিক মায়েলয়েড লিউকেমিয়া যিমানেই ভয়ংকৰ নহওক কিয় যদি সঠিকভাৱে ৰোগ চিহ্নিত কৰা হয় তেতিয়া ৰোগীৰ বাচি থকাৰ সম্ভাৱনা বাঢ়ে৷ প্ৰকৃততে কৰ্কট সদায়ে দেৰীকৈ ধৰা পৰে৷ সেয়ে চিকিৎসাই কামত নিদিয়ে৷
এনেধৰণৰ অন্যান্য বা-বাতৰিৰ বাবে লাইক কৰক অসম লাইভ ২৪ ৰ ফেচবুক পেজ